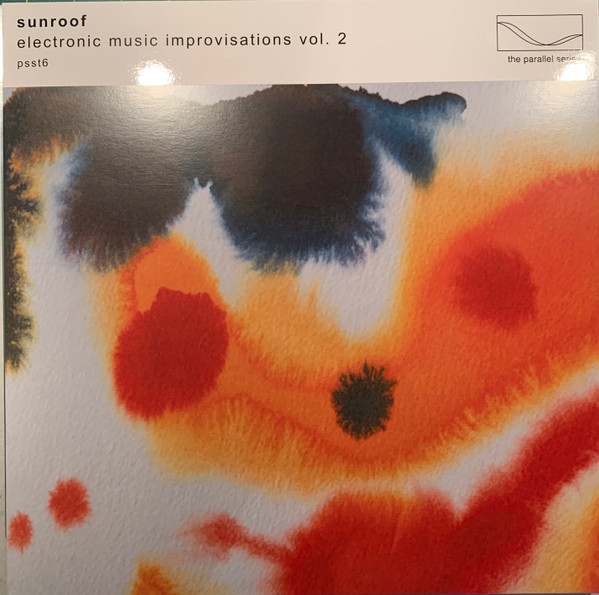
SUNROOF — ELECTRONIC MUSIC IMPROVISATIONS, VOL. 2

Catalogue
SUNROOF — ELECTRONIC MUSIC IMPROVISATIONS, VOL. 2
PSST6
image for reference only - variations may occur
- Format
- Vinyl
- Label
- Mute
- Stock
- 99 available
- Price (shop)
- £14.64
Find this release on the home search, add it to your basket, and check out with Stripe. The price shown is the current shelf price; postage is added at checkout.